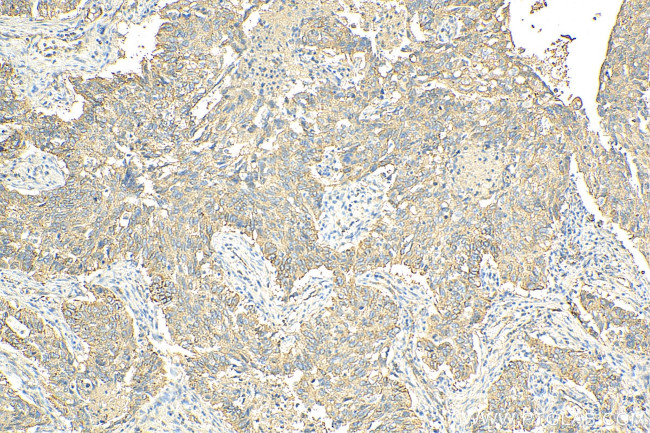
MARCKSL1 Antibody in Immunohistochemistry (Paraffin) (IHC (P))

Search
Proteintech
MARCKSL1 Polyclonal Antibody
{{$productOrderCtrl.translations['antibody.pdp.commerceCard.promotion.promotions']}}
{{$productOrderCtrl.translations['antibody.pdp.commerceCard.promotion.viewpromo']}}
{{$productOrderCtrl.translations['antibody.pdp.commerceCard.promotion.promocode']}}: {{promo.promoCode}} {{promo.promoTitle}} {{promo.promoDescription}}. {{$productOrderCtrl.translations['antibody.pdp.commerceCard.promotion.learnmore']}}
产品信息
11422-1-AP
种属反应
已发表种属
宿主/亚型
分类
类型
抗原
偶联物
形式
浓度
规格
纯化类型
保存液
内含物
保存条件
运输条件
产品详细信息
Immunogen sequence: MGSQSSKAP RGDVTAEEAA GASPAKANGQ ENGHVKSNGD LSPKGEGESP PVNGTDEAAG ATGDAIEPAP PSQGAEAKGE VPPKETPKKK KKFSFKKPFK LSGLSFKRNR KEGGGDSSAS SPTEEEQEQG EIGACSDEGT AQEGKAAATP ESQEPQAKGA EASAASEEEA GPQATEPSTP SGPESGPTPA SAEQNE (1-195 aa encoded by B C007904)
靶标信息
MARCKS (Myristoylated alanine-rich protein kinase C substrate), also designated 80K or 80K-L, is a 332 amino acid protein that localizes to the plasma membrane and functions as a major cellular substrate for protein kinase C (PKC). MARCKSL1 (MARCKS-like protein 1), also known as MacMARCKS, MLP, MRP, or F52, is a 195 amino acid protein that, like MARCKS, is a major substrate for PKC. Expressed in a variety of tissues with highest levels found in testis and uterus, MARCKSL1 participates in the coordination of membrane-cytoskeletal signaling events, including secretion, migration, phagocytosis and cell adhesion. Additionally, MARCKSL1 functions as a regulator of Integrin activation and is thought to regulate Integrin-dependent signal transduction pathways, especially those involved in macrophage spreading.
仅用于科研。不用于诊断过程。未经明确授权不得转售。
生物信息学
蛋白别名: Mac-MARCKS; MacMARCKS; Macrophage myristoylated alanine-rich C kinase substrate; MARCKS-like protein 1; MARCKS-related protein
基因别名: F52; MACMARCKS; MARCKSL1; MLP; MLP1; MRP
UniProt ID: (Human) P49006
Entrez Gene ID: (Human) 65108